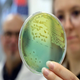
Posledice vojne: Ukrajina je postala gojišče super bakterij, proti katerim so vsi antibiotiki nemočni!
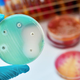
Zaradi superbakterij bo Covid videti »neznaten«, opozarja strokovnjakinja

Novice protimikrobna zdravila
Zadnjih 5 novic
- 36-letnica, ki jo minuta sonca spravi v bolnišnico, živi kot vampirka Dnevnik · 2t
- Pijače in zdravila: preverite, katerim kombinacijam se je bolje izogniti Primorske novice · 7M
- Samooskrba in varnost hrane: ob morebitni krizi bi hitro nastopile težave RTV Slovenija · 8M
- Prodaja protimikrobnih zdravil za živali lani glede na 2022 manjša za 10 odstotkov STA · 1L
- Ob evropskem dnevu antibiotikov opozorili na protimikrobno odpornost STA · 1L
36-letnica, ki jo minuta sonca spravi v bolnišnico, živi kot vampirka

Večina ljudi komaj čaka, da se dan začne daljšati in da čim večkrat posije sonce. Izjema je 36-letna Emily Richardson , in to z dobrim razlogom. Že po 30 sekundah … · Dnevnik · 2t
stevens-johnsonov sindrom bolezen emily richardson objavi tvitaj
Pijače in zdravila: preverite, katerim kombinacijam se je bolje izogniti

Zdravila, ki jih jemljemo v obliki tablet ali kapsul, je večinoma treba zaužiti cela s kozarcem tekočine. Ob tem se nemalokrat pojavi dilema, katero tekočino uporabiti. · Primorske novice · 7M
Samooskrba in varnost hrane: ob morebitni krizi bi hitro nastopile težave
Novice / Okolje
Slovenija ni samooskrbna s hrano, niti nima določene najmanjše stopnje samooskrbnosti potrebne za preskrbo prebivalstva s hrano. V primeru večje krize bi tako hitro nastopile težave. Vprašanje samooskrbe in prehranske … · RTV Slovenija · 8M
kmetijska zemljišča kriza prehranska varnost samooskrbnost samooskrba objavi tvitaj
To so zaskrbljujoča dejstva o antibiotikih
Novice / Zdravje
Ob evropskem dnevu antibiotikov so zdravstveni strokovnjaki opozorili na protimikrobno odpornost in pretirano uporabo antibiotikov. Ob letošnjem evropskem dnevu antibiotikov, ki ga zaznamujemo danes, je v ospredju vprašanje odpornosti mikrobov … · Žurnal24 · 1L
Zakaj se sodobni otroci ne morejo znebiti glistavosti

Nadloga, ki jo tableta uspešno odstrani, a se pogosto vrača tudi zaradi nedoslednosti staršev Ena izmed nadlog, s katero se vsaj posredno sreča precej staršev majhnih otrok, so še vedno … · Večer · 1L
Posledice vojne: Ukrajina je postala gojišče super bakterij, proti katerim so vsi antibiotiki nemočni!
Novice / Svet
Ukrajina je postala gojišče super bakterij, proti katerim so vsi antibiotiki nemočni! Težava je tako resna, da je postala celo glavna novica v The Sunday Timesu! Novico je sprožila amputacija … · Insajder · 1L
Zaradi superbakterij bo Covid videti »neznaten«, opozarja strokovnjakinja
Novice / Svet
Superbakterije - patogeni, ki so razvili odpornost na zdravila, ki se uporabljajo za njihovo zdravljenje - bodo poskrbele, da bo pandemija Covida v primerjavi z njimi videti »neznatna«. Tako pravi … · Slovenske novice · 1L
odpornost okužba koronavirus zdravje zdravila epidemija zloraba virusi bolezen antibiotik smrt objavi tvitaj
Z obiskom in uporabo spletnega mesta soglašate s piškotki.